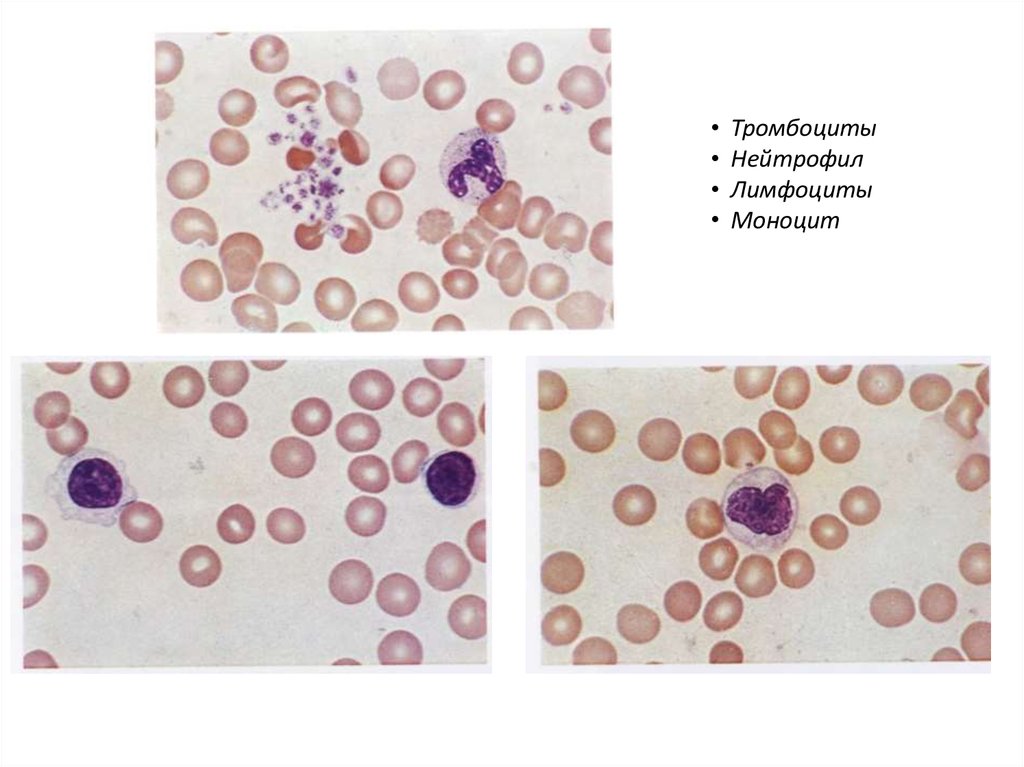
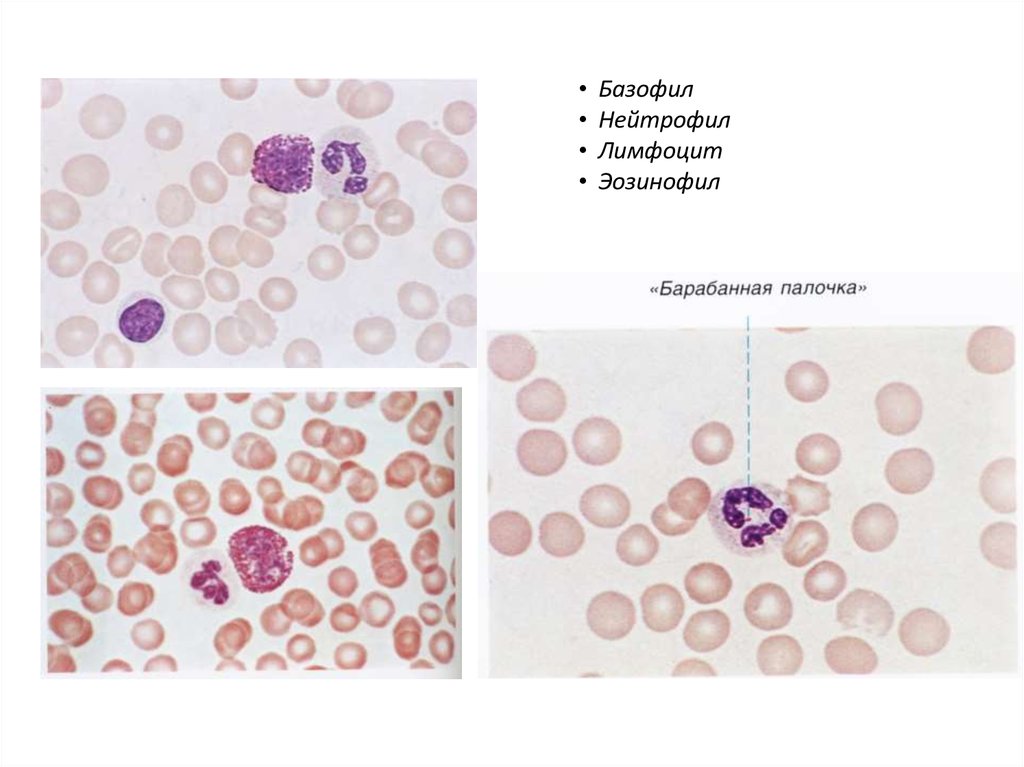
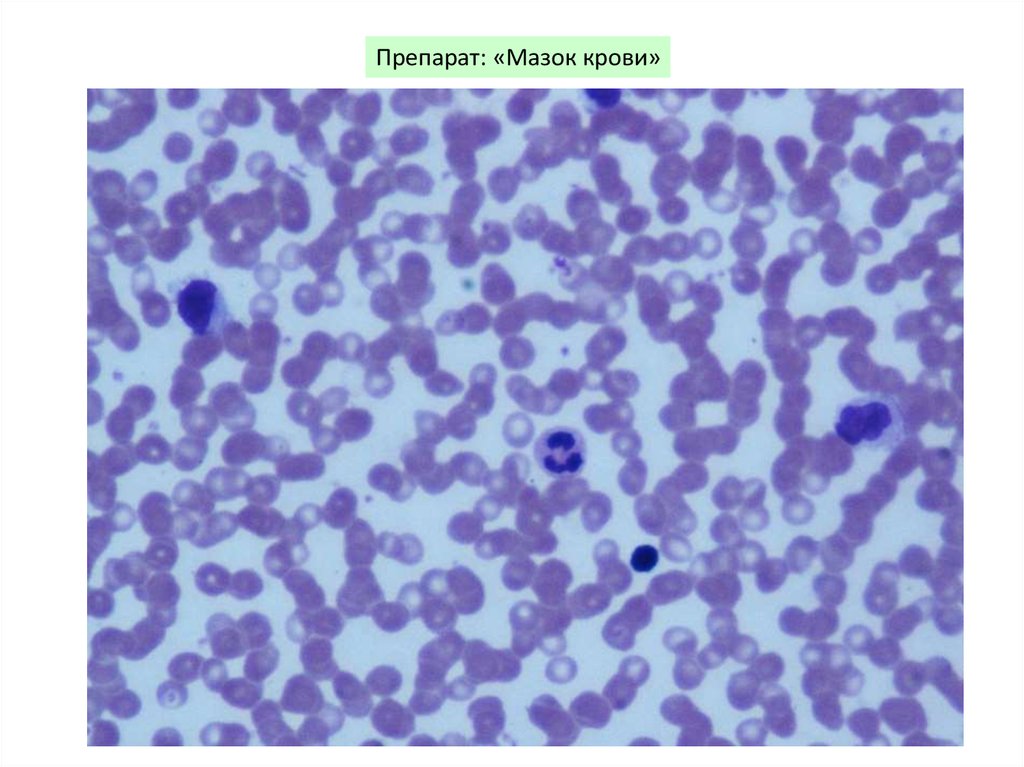
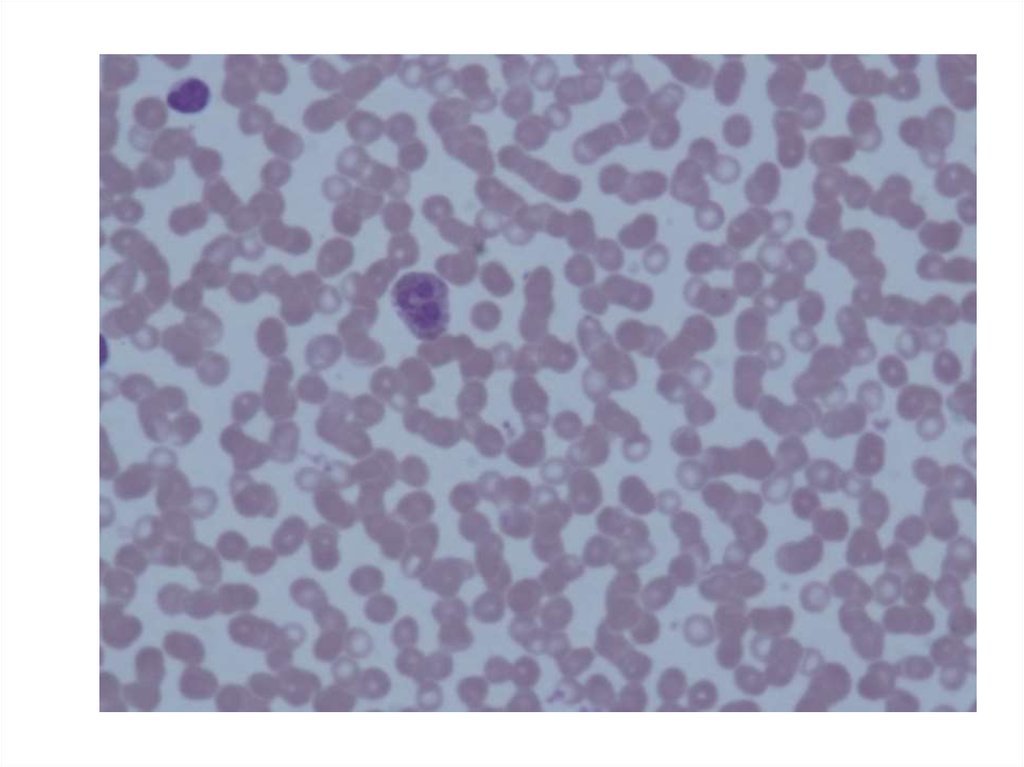
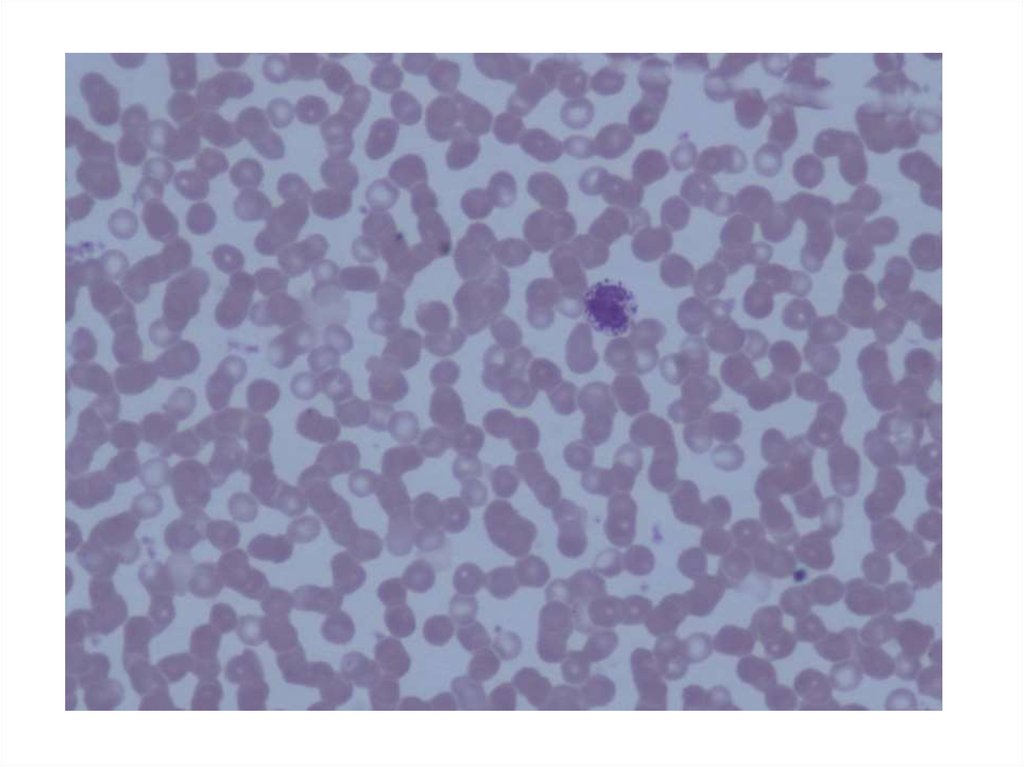
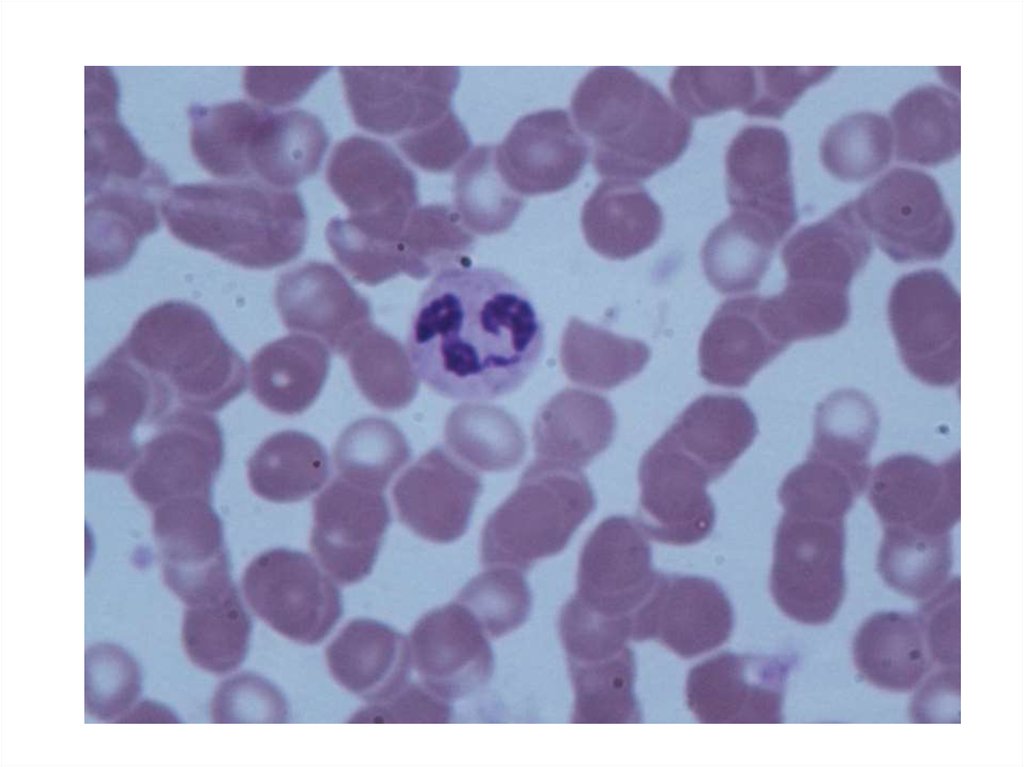
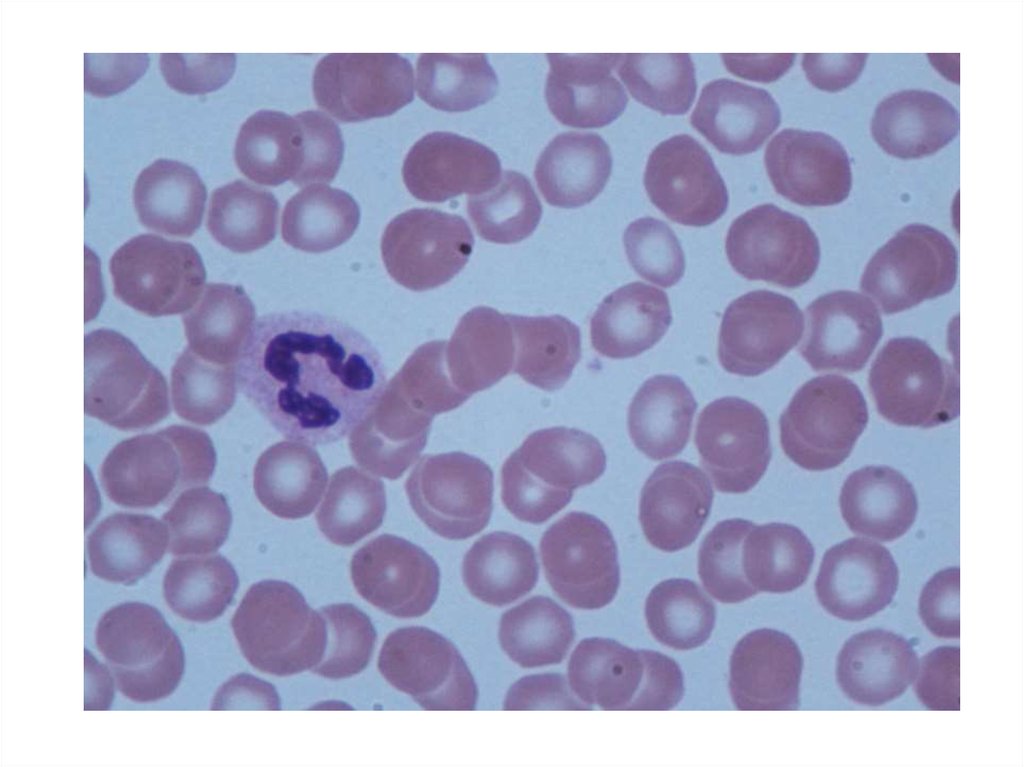
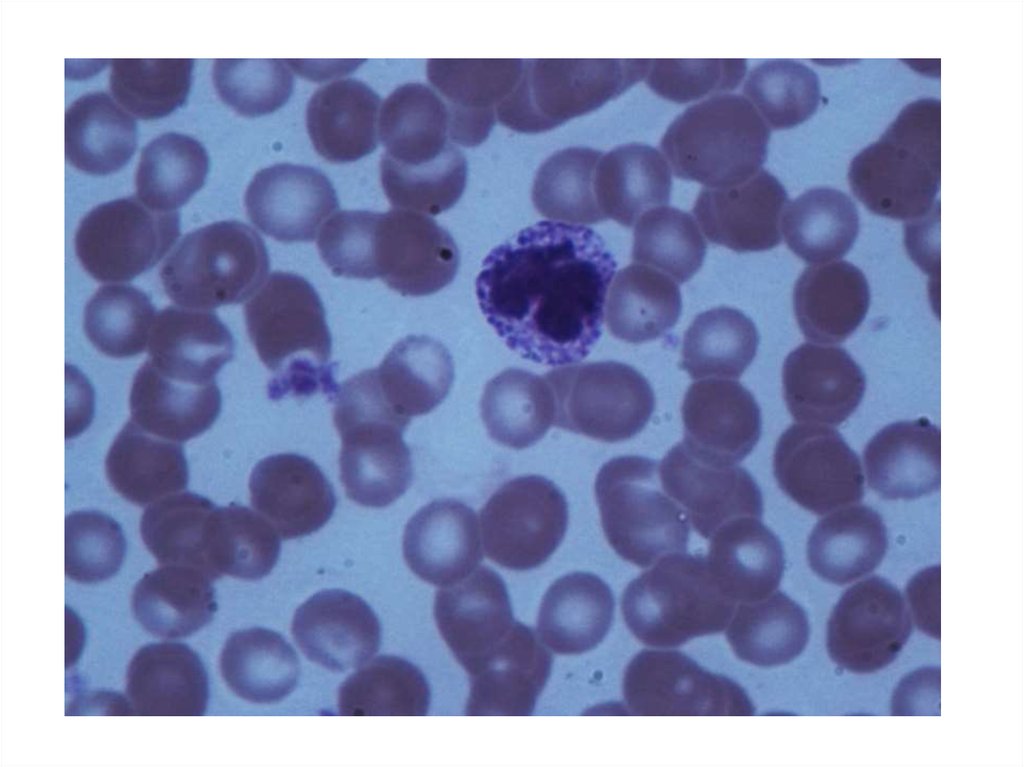
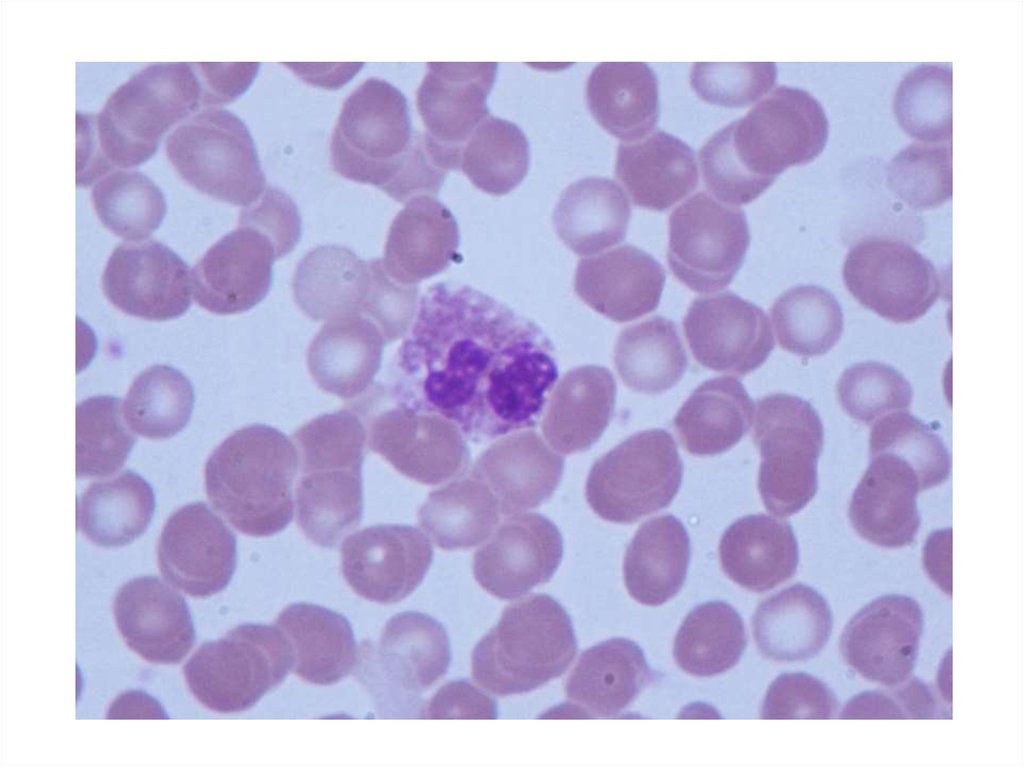
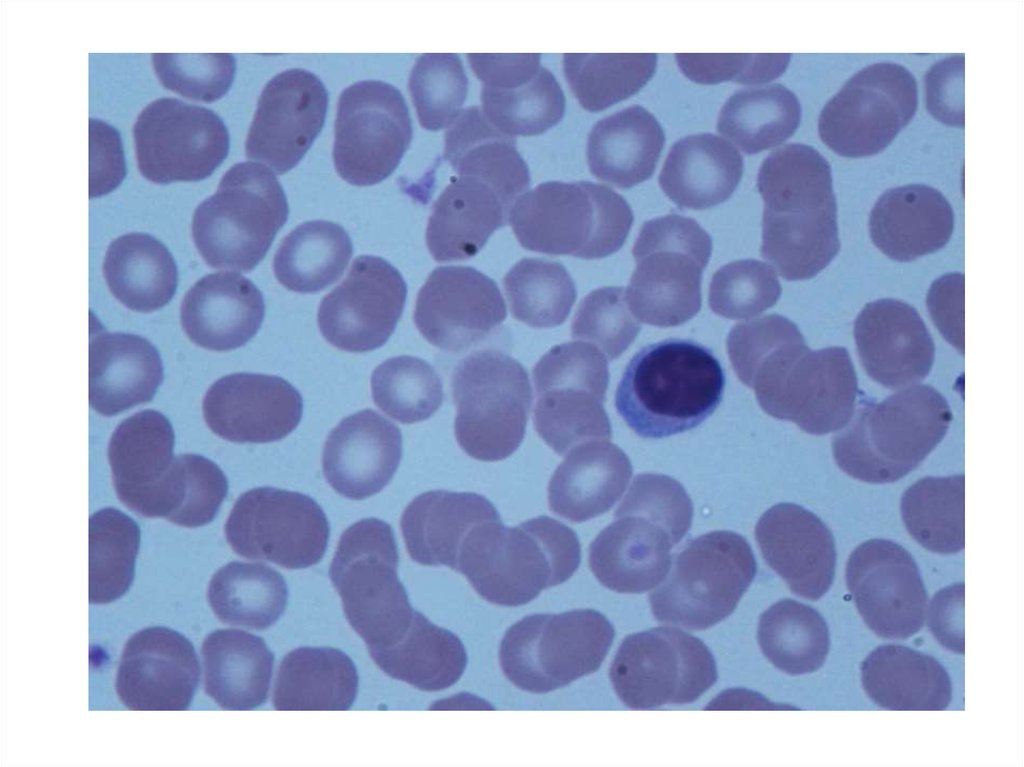
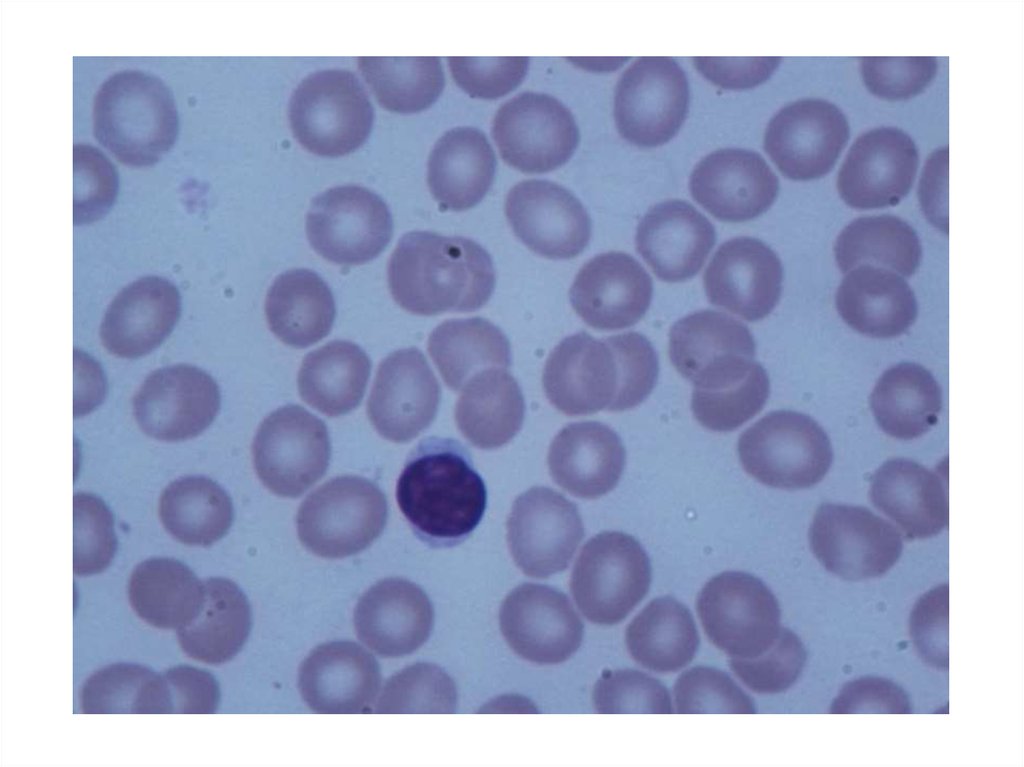
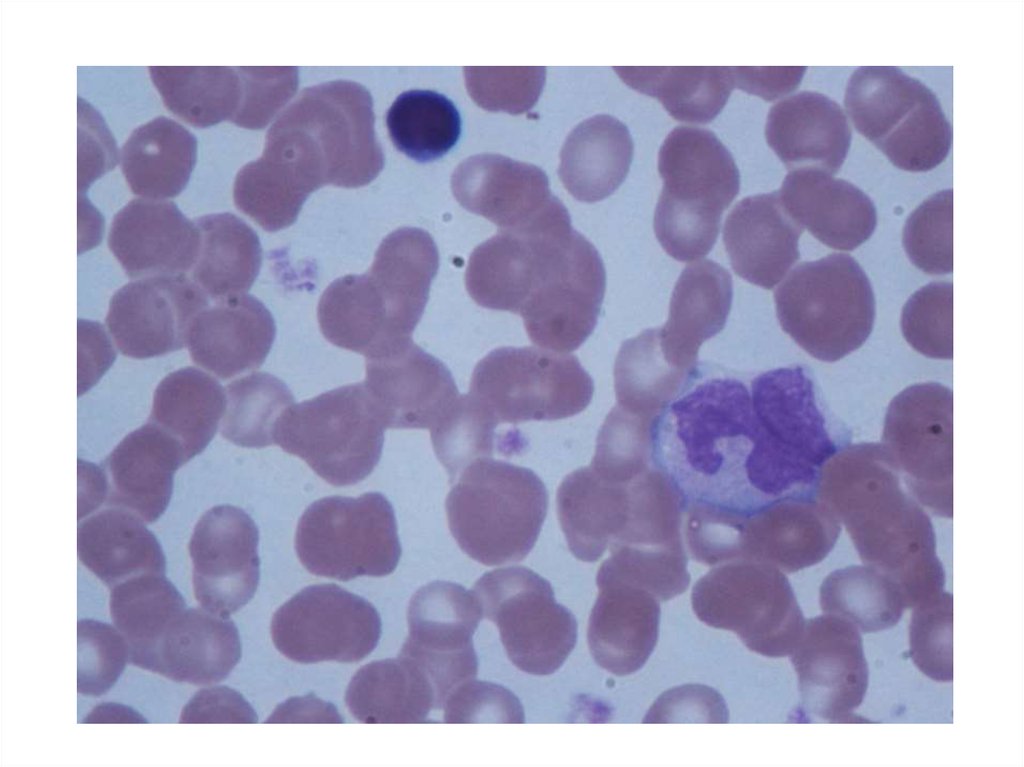
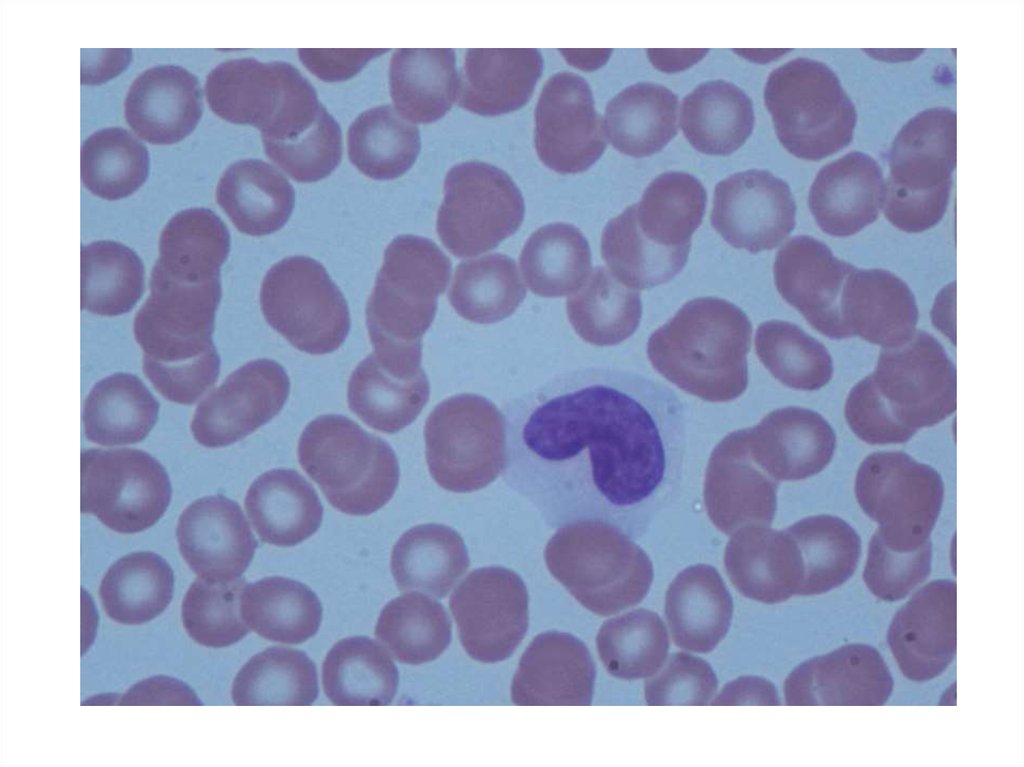
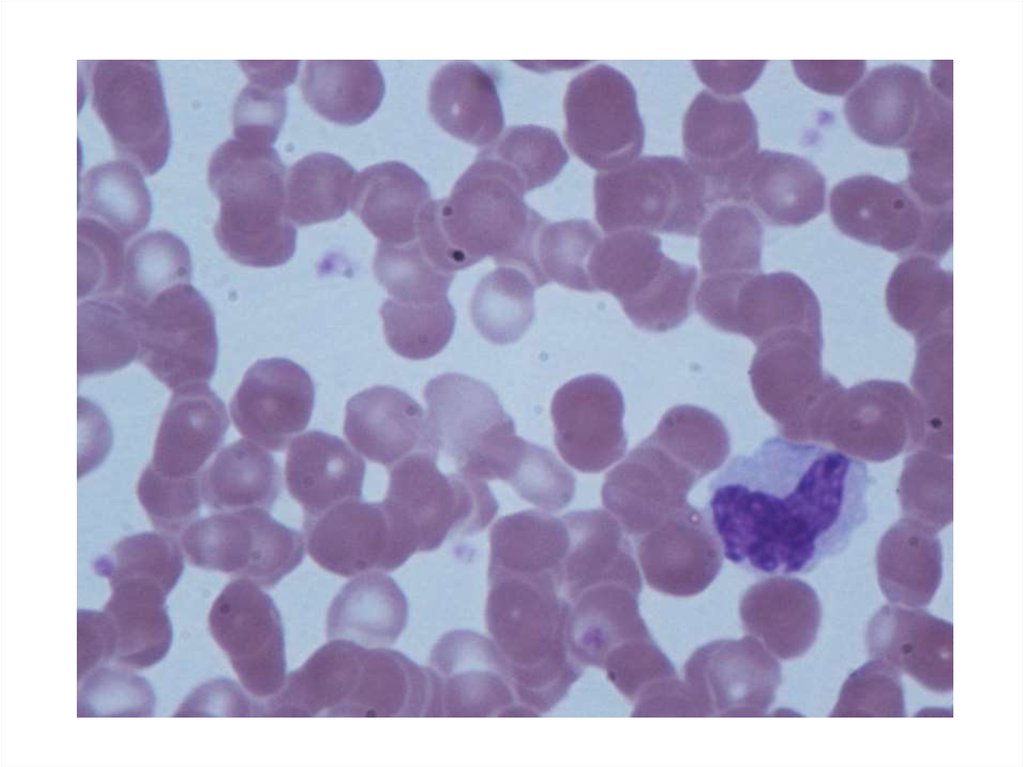
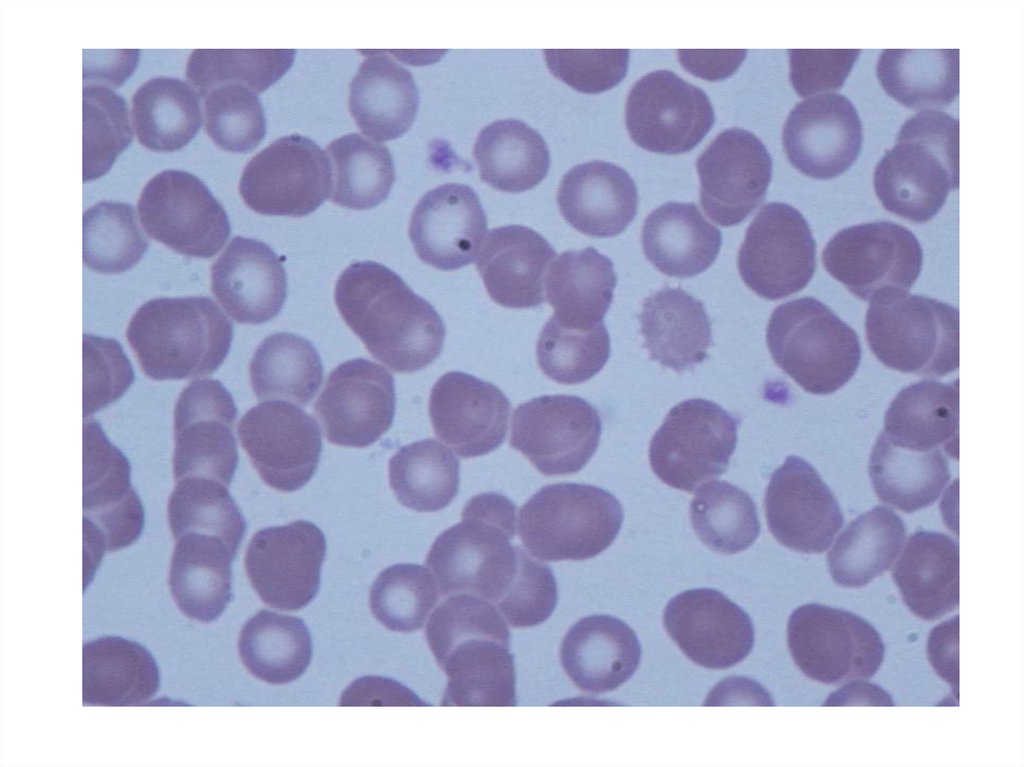

Similar presentations:
Ткани внутренней среды
1.
Все ткани внутренней среды характеризуются рядом особенностей строения:- удаленность клеток друг от друга,
- отсутствие межклеточных контактов,
- много межклеточного вещества,
- развитие из мезенхимы
2.
Эритроцитыи
тромбоциты
3.
Строение тромбоцитаА - горизонтальный срез; Б - поперечный срез.
1 - плазмолемма; 2 - открытая система каналов; 3 - актиновые филаменты; 4 - циркулярные пучки микротрубочек;
4а - микротрубочки в поперечном разрезе; 5 - плотная тубулярная система; 6 - a-гранулы; 7 - d-гранулы; 8 митохондрии; 9 - гранулы гликогена; 10 - гранулы ферритина; 11 - лизосомы; 12 - пероксисомы.
4.
Плазмолемма эритроцита.1-плазмолемма, 2- белок полосы 3, 3- гликофорин, 4- спектрин, 5- анкирин,
6- белок полосы 4.1, 7- актин.
5.
Лейкоцитарная формулаЛейкоциты
Агранулоциты
Лимфоциты
19-37%
Гранулоциты
Моноциты
3-11%
Нейтрофилы
48-78%
Юные
0-0.5%
Палочкоядерные
1-6%
Эозинофилы
0.5-5%
Сегментоядерные
47-72%
Базофилы
0-1%
6.
Cтроение гранулоцитовА
Б
В
А — сегментоядерный нейтрофил; Б — эозинофил; В – базофил:
1 — сегменты ядра; 2 — тельце полового хроматина; 3 — первичные (азурофильные) гранулы; 4 —
вторичные (специфические) гранулы; 5 — зрелые специфические гранулы эозинофила, содержащие
кристаллоиды; 6 — гранулы базофила различной величины и плотности; 7 — периферическая зона, не
содержащая органелл; 8 — микроворсинки и псевдоподии.
7.
• Базофил• Эозинофил
• Нейтрофил
8.
Строение агранулоцитовА — лимфоцит; Б — моноцит: 1 —ядро; 2 —микроворсинки
9.
Лимфоциты: малый и большойМоноцит
10.
Нейтрофил11.
Эозинофил12.
Базофил13.
Лимфоцит14.
Моноцит15.
Тромбоциты
Нейтрофил
Лимфоциты
Моноцит
16.
Базофил
Нейтрофил
Лимфоцит
Эозинофил

biology
biology








